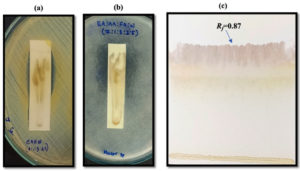

ISSN: 0973-7510
E-ISSN: 2581-690X
The present study focused on identifying antimicrobial and antioxidant bioactive fraction from Syzygium cumini leaf extract. Initial screening through contact-thin layer chromatography (TLC) bioautography identified active regions, which were subsequently subjected to partial purification by preparative TLC (PTLC). This partially purified fraction was characterized using UV-Visible (UV-Vis) Spectroscopy, ATR-FTIR, and GC-MS. Antimicrobial activity against Staphylococcus aureus and Mucor species was evaluated using the disc diffusion assay, while antioxidant potential was assessed through the DPPH radical scavenging assay. The solvent system containing ethyl acetate, acetic acid, formic acid, and water (7:1:3:2.5) successfully separated a distinct chromatographic spot exhibiting antimicrobial activity. UV-Vis analysis exhibited a λmax peak at 224 nm. ATR-FTIR spectra revealed the presence of functional groups, including O-H (phenols), C=C (aromatic rings), and C=C (alkynes), suggesting a phenolic nature of the compounds. GC-MS analysis identified 17 compounds within this bioactive fraction. Notably, this purified fraction demonstrated significant antimicrobial properties, with inhibition zones of 21.77 ± 0.68 mm against S. aureus and 24.93 ± 0.80 mm against Mucor sp., and also possessed significant antioxidant activity (IC50 value of 56.75 µg/mL).
Bioactive Fraction, Syzygium cumini Leaf, Contact-TLC Bioautography, Preparative TLC, UV-visible Spectroscopy, ATR-FTIR, GC-MS Analysis
Plants represent a prolific reservoir of bioactive lead compounds and molecular scaffolds with considerable therapeutic and nutraceutical potential.1 Various parts of the plant not only contribute to the human diet but also serve as pharmacologically safe sources for the prevention and management of a wide spectrum of human diseases.2 In the current era, interest in plants has seen a notable resurgence and continues to grow, with the pharmaceutical industry increasingly acknowledging plants as a valuable source of structurally diverse lead compounds for drug discovery.3 Notably, natural products have been associated with the development of approximately 44% of newly approved pharmaceuticals, frequently serving as scaffolds for the development of semi-synthetic derivatives.4 In pursuit of bioactive compounds, numerous research efforts have focused on the systematic screening of plant extracts to detect secondary metabolites with interesting biological properties.3 Rapid detection and screening of bioactive compounds are pivotal in natural product research. Traditional methods, which involve isolating compounds and subsequent activity testing, can be inefficient, especially when bioactive compounds are present in low quantities or lose their activity during isolation.5 Therefore, rapid and accurate screening techniques are vital for identifying bioactive substances and ensuring quality control. Thin layer chromatography bioautography offers a cost-effective, sensitive, and reliable approach with fast-paced development to isolate and evaluate bioactive components. Combining TLC separation with bioactivity assessment, this technique enables the localization of active compounds and is widely employed for detecting antibacterial, antifungal, antioxidant, and enzyme-inhibitory activities.6
Antimicrobials are the substances obtained naturally, synthetically, or semi-synthetically that inhibit the growth or viability of microorganisms.7 Antibiotics are commonly used for the treatment of bacterial infections in humans and animals.8 Despite existing antimicrobial agents, the continuous emergence of resistant microorganisms underscores the critical necessity for the finding and advancement of novel drugs.3 Overuse, misuse, and genetic mutations in microbial populations contribute to the development of drug-resistant pathogens, rendering antibiotics ineffective.9 Fungal and bacterial pathogens are responsible for severe infectious diseases in humans and animals, and among immunocompromised individuals.3 Antibiotic-resistant infections lead to substantial morbidity, mortality, and economic burdens on global healthcare systems.10,11 The growing ineffectiveness of antibiotics and increasing antibiotic resistance in pathogenic bacteria has intensified the exploration of plants as promising sources for novel antimicrobials to combat resistant pathogens.12
Free radicals are unstable molecules with an unpaired electron in an atomic orbital, which makes them highly reactive as they seek to pair the electron by interacting with other molecules. These highly reactive species can act as either oxidizing or reducing agents by transferring electrons to or from other molecules.13 In addition to the normal metabolic processes occurring within the body, external factors such as exposure to ionizing radiation, air pollution, tobacco smoke and hazardous chemicals can also produce free radicals and reactive oxygen species (ROS).14 Excessive free radical production can lead to secondary cellular damage as well as direct oxidative damage to critical biomolecules.15 Antioxidants play a critical role in mitigating the development of various diseases, including cancer, cardiovascular conditions, neurological disorders, aging and inflammation. Natural plant-derived compounds are considered potent antioxidants, offering protective effects against the cellular damage induced by free radicals.16
S. cumini is an indigenous to tropical Asia, particularly India. This plant is widely recognized for its diverse pharmacological potential, primarily due to the diverse bioactive constituents present in its various parts.17 The leaves are utilized in the treatment of skin disease, stomach problem, constipation, white discharge, and diabetes, with their ash employed to strengthen teeth and gums, dysentery, paediatric diarrhoea.18,19 Pharmacological research has highlighted its antioxidant,20 antibacterial,21,22 antifungal,22 antihyperglycemic,23 anti-inflammatory activities,23,24 underscoring the need for continued screening of natural sources for new therapeutic leads. The present study focuses on isolating antimicrobial active fraction, purify them, and characterizing them through UV, FTIR, and GC-MS analyses, followed by evaluation of their antimicrobial and antioxidant potential.
Plant extraction procedure
Leaves of S. cumini were collected from Perumbakkam, Chennai, Tamil Nadu and were authenticated by Dr. P. Palani at the Centre for Advanced Studies in Botany, University of Madras, Chennai, Tamil Nadu. A voucher specimen has been deposited under the reference number MUBL1135. Then, leaves of S. cumini were properly washed with distilled water. The cleaned leaves were then shade-dried at room temperature to preserve sensitive phytoconstituents. The leaves were ground into powder using a grinder. Precisely 5 grams of the powdered leaf material was mixed with 50 mL of distilled water and subjected to aqueous extraction at 60 °C for 2 hours. Then, the extract was filtered, and stored in sterile, airtight containers at 4 °C for further study.22
Separation, detection and purification of antibacterial and antifungal fraction
Analytical TLC (ATLC) for the separation of fraction
ATLC was performed using silica gel 60 F254 plates. Freshly prepared S. cumini leaf extract was carefully spotted onto the silica surface and allowed to air-dry. The chromatographic plates were then developed using different solvent systems as mobile phase, including Toluene: Ethyl acetate: Formic acid (T:EA:FA) in the ratio of 7:2:1, Chloroform: Ethyl acetate: Formic acid (C:EA:FA) in the ratio of 5:4:1, Ethyl acetate: Acetic acid:Formic acid: Water EA:AA:FA:W in the ratio of 7:1:3:2.5, Chloroform: Methanol (C:M) in the ratio of 4:1, Chloroform: Acetic acid: Methanol:Water (C:AA:M:W) in the ratio of 64:32:12:8, and Toluene: Ethyl acetate: Formic acid: Water (T:EA:FA:W) in the ratio of 3:3:0.8:0.3. Each chamber was pre-saturated with the respective solvent system for 30 minutes to ensure optimal resolution. After development, the plates were dried at room temperature and the separated fraction was visualized under visible light and by exposure to iodine vapours. The retention factor (Rf) value of the separated fraction was subsequently calculated.25
Contact-TLC bioautography for antimicrobial bioactivity detection
Contact bioautography was done according to Annuryanti et al. with modifications to evaluate the antimicrobial activity of the fraction separated on the TLC plate.26 The bioautographic evaluation was conducted using Staphylococcus aureus and Mucor sp. as the test organisms. Freshly prepared inocula were standardized to a concentration of 1 × 106 CFU/mL for S. aureus and 1×10⁶ spores/mL for Mucor sp. Uniform lawn cultures were made on sterile Mueller-Hinton Agar (MHA) plates. The developed TLC plates, containing the separated compounds, were carefully placed in direct contact with the inoculated agar surfaces, then, incubated overnight at 37 °C for S. aureus plate, while the Mucor sp. plate at room temperature for three days. Then, inhibition zones (IZ), observed as clear areas on the agar where microbial growth was suppressed, indicated the presence of bioactive antimicrobial compounds.
PTLC for Purification
Crude extract was introduced to a PTLC glass plate (20 × 20 cm). After allowing the plate to air-dry, chromatographic separation was carried out using EA:AA:FA:W (7:1:3:2.5) as a mobile phase (it had proven effective in resolving bioactive antibacterial and antifungal fraction). Then, the plate was kept inside a pre-saturated glass chamber to ensure optimal separation, then dried under ambient conditions. The chromatographic band corresponding to the active compound (based on Rf value consistency with analytical TLC) was carefully scraped from the plate. The collected silica containing the purified fraction was suspended in distilled water, then, centrifuged for 15 minutes at 12,000 rpm and the supernatant was collected. Subsequently, it was lyophilized to obtain the purified fraction in dry form. This purified, dried sample was stored under appropriate conditions for subsequent characterization and bioactivity evaluation.25
Characterization of Purified Fraction
UV-Vis Spectroscopy
The UV-Vis absorption spectrum of the fraction was detected using a spectrophotometer (Agilent Technologies, Cork, Ireland) over a wavelength range of 190 to 600 nm. This spectral range was selected to capture both the ultraviolet and visible light regions, allowing for the detection of characteristic absorbance peaks that may indicate the presence of conjugated systems or chromophoric functional groups typically associated with phenolic or flavonoid compounds. The observed absorption peaks were subsequently analysed using Origin software to determine the λmax (maximum absorption wavelength), which provides preliminary insight into the compound’s structural features and electronic transitions.
FT-IR spectroscopy analysis
FTIR spectra of purified fraction from S. cumini leaf extract was recorded using ATR-FTIR spectrophotometer (Bruker Optik Alpha T with ATR, Germany) region from 4000 to 500 cm-1.
GC-MS analysis
GC-MS analysis was carried out to detect the compound from the fraction. It was performed using a GCMS-QP2010 Ultra system (Shimadzu, Japan), equipped with an Rtx-5MS fused silica capillary column (30 m × 250 µm i.d., film thickness 0.25 µm; 5% diphenyl, 95% dimethylpolysiloxane). The injector was operated at 250 °C in split mode, with a split ratio of 1:50. A 1 µL aliquot of the sample was injected, and helium was used as the carrier gas at a constant flow rate of 1.0 mL/min. The oven temperature was programmed as follows: an initial temperature of 80 °C was held for 4 minutes, followed by a gradual increase to 100 °C at a rate of 2 °C/min. Subsequently, the temperature was raised to 280 °C at a rate of 5 °C/min and held for 5 minutes. The total run time was 54 minutes. Identification of compounds was carried out by comparing the obtained mass spectra with reference spectra from Wiley 8 and NIST 11 and 17 libraries.
Antimicrobial activity
Antimicrobial potential of the purified fraction from S. cumini leaf extract and standard antibiotic and antimycotic drugs against S. aureus and Mucor sp. were further determined by disc diffusion method.27 100 µl each of 106 CFU/ml of bacterial culture and 106 spore/ml of fungal culture were seeded onto the respective MHA plates.
5 mg of purified fraction was added into the disc. Nystatin (100 units) and Ciprofloxacin (5 mcg) were utilised as a standard drug. Zone of inhibition was determined following incubation for 24 hrs at 37 °C (bacterial culture) and room temperature for 72 hrs (fungal culture) respectively. The assay was conducted in triplicates.
Antioxidant activity
The antioxidant potential of the purified fraction was quantitatively determined through the 2,2-diphenyl-1-picrylhydrazyl (DPPH) radical scavenging assay.2 Different concentrations of the partially purified compound were prepared. Each concentration was mixed with an equal volume of 0.004% (w/v) methanolic DPPH solution (0.1 mM). Ascorbic acid served as the positive control. The reaction mixtures were subjected to vigorous agitation and placed in the dark condition at 28 °C for 30 minutes. The negative control was prepared by combining distilled water with the DPPH solution. Absorbance readings were taken at 517 nm and the percentage of inhibition was determined using the following calculation:
Inhibition % = Absorbance of control-Absorbance of purified compounds / Absorbance of control × 100
Statistical analysis
Antibacterial and antioxidant activity data were expressed as mean ± SD and analysed using one way ANOVA (SPSS software version 25). p ≤ 0.05 was considered statistically significant.
Analytical TLC
Analytical TLC was performed to separate the fraction in the SC leaves. Six solvent systems were used to run the TLC for separation of fraction (Figure 1). The separated spot of the SC leaves on the TLC plate were visualized after iodine treatment. T:EA:FA (7:2:1) was unable to separate the spot. C:EA:FA (5:4:1) was also unable to separate the spot. EA:AA:FA:W (7:1:3:2.5) was able to separate one spot at Rf = 0.87. T:EA:FA:W (3:3:0.8:0.3), C:AA:M:W (64:32:12:8) and C:M (4:1) were unable to separate the spot.
Figure 1. Analytical TLC of SC leaves using different solvent systems: (a) T:EA:FA (7:2:1), (b) C:EA:FA (5:4:1), (c) EA:AA:FA:W (7:1:3:2.5), (d) C:M (4:1), (e) C:AA:M:W (64:32:12:8), (f) T:EA:FA:W (3:3:0.8:0.3)
Contact-TLC bioautography of fraction from S. cumini leaves for antimicrobial bioactivity screening and its purification
Out of the six solvent systems, only one solvent system – EA:AA:FA:W (7:1:3:2.5) was able to separate the spot (Rf = 0.87) from SC leaves. The antimicrobial bioactivity screening was performed for the separated spot against S. aureus (Figure 2a) and Mucor sp. (Figure 2b) using contact-TLC bioautography. The spot with Rf value of 0.87 exhibits inhibition zone on both the plates inoculated with S. aureus and Mucor sp. indicating the antimicrobial activity. As the solvent system, EA:AA:FA:W (7:1:3:2.5) was able to separate antimicrobial active fraction, preparative TLC was carried out using this solvent system and the antimicrobial active fraction was purified (Figure 2c). In consistent with our finding, antimicrobial bioactive compound from Himanthalia elongata Brown Seaweed was detected using TLC bioautography.25 Similarly, antimicrobial compounds produced by phytobiological endosymbionts inhabiting Azadirachta indica L. were characterized via bioautography.28
Figure 2. (a) Contact-TLC bioautography for antibacterial bioactivity detection against S. aureus (b) Contact-TLC bioautography for antifungal bioactivity detection against Mucor sp. (c) Purification using PTLC
Characterization of partial purified compound
UV-Vis spectroscopy
UV-Vis spectroscopy analysis was used to characterize the purified fraction from S. cumini leaf extract. Phenolic compounds are characterized by their UV absorbance within the wavelength range of 220 to 400 nm.29 The spectrum of the analysed fraction exhibited characteristic absorption peaks at 224 nm and 264 nm (Figure 3). It showed λmax peak at 224 nm. For instance, the existence of phenolic compounds in the extracts of S. japonica var. fortunei flowers and leaves was confirmed by the peaks in the region of 210-320 nm.30
ATR-FTIR analysis
The functional groups present in the purified bioactive fraction from S. cumini leaf extract was identified by ATR-FTIR analysis. The absorption spectra of the fraction obtained are depicted in Figure 4. It showed a stretching band pattern at 3299 cm-1, 2127.48 cm-1 and 1639 cm-1. The FTIR spectra are interpreted by observing the banding patterns. Strong band at 3299 indicates polymeric hydroxyl groups (O-H), a characteristic of polyphenolic compounds,31 weak band at 2127.48 indicates C=C stretching (alkyne) and strong band at 1639 indicates aromatic C=C stretching (alkene).32 By observing the band pattern, the purified fraction might be phenolic compounds.
GC-MS analysis
The GC-MS chromatogram of purified fraction from S. cumini leaves, depicted in Figure 5, revealed the presence of 17 distinct compounds, as detailed in Table. Among these, cis-9-hexadecenal was the most abundant, comprising 29.99% of the total composition. Ethyl (9z,12z)-9,12-octadecadienoate comprised of 18.09%, trilinolein comprised of 8.61%, dodecanoic acid 1,2,3-propanetriyl ester comprised of 7.56%, glycidol stearate comprised of 5.64%, 9-Octadecenoic acid, methyl ester, (E)- comprised of 1.31%, etc. Cis-9-Hexadecenal exhibits antifungal activity,33 antioxidant34 and anti-inflammatory activities.34 Ethyl (9z,12z)-9,12-octadecadienoate has antibacterial and anticancer activity.35 9-Octadecenoic acid, methyl ester, (E)- has antibacterial and antioxidant activities.12 Dodecanoic acid, 1,2,3-propanetriyl ester has antioxidant, antibacterial, hepatoprotective hypocholesterolemic properties.36 Trilinolein has antioxidant activity.37 Hexadecanoic acid, methyl ester has antimicrobial, anticancer, antiarthritic, antihistaminic, properties.38,39
Table:
Compounds detected through GC-MS analysis
Peak |
Retention Time |
Area % |
Compounds |
IUPAC name |
|---|---|---|---|---|
1 |
34.819 |
0.31 |
Hexadecanoic acid, methyl ester |
Methyl hexadecanoate |
2 |
38.469 |
0.94 |
9,12-Octadecadienoic acid (Z,Z)-, methyl ester |
Methyl (9Z,12Z)-octadeca-9,12-dienoate |
3 |
38.616 |
1.31 |
9-Octadecenoic acid, methyl ester, (E)- |
Methyl (E)-octadec-9-enoate |
4 |
39.147 |
0.16 |
Octadecanoic acid, methyl ester |
Methyl octadecenoate |
5 |
39.466 |
29.99 |
cis-9-Hexadecenal |
(Z)-hexadec-9-enal |
6 |
41.245 |
0.20 |
Palmitoyl chloride |
Hexadecanoyl chloride |
7 |
42.840 |
0.20 |
6,9-Octadecadienoic acid, methyl ester |
Methyl (6Z,9Z)-octadeca-6,9-dienoate |
8 |
42.949 |
0.18 |
9-Octadecenamide |
Octadec-9-enamide |
9 |
43.836 |
0.73 |
9,12-Octadecadienoic acid (Z,Z)-, 2,3-dihydroxypropyl ester |
2,3-dihydroxypropyl (9Z,12Z)-octadeca-9,12-dienoate |
10 |
43.923 |
0.91 |
Oleoyl chloride |
(Z)-octadec-9-enoyl chloride |
11 |
44.532 |
12.85 |
Ethyl (9z,12z)-9,12-octadecadienoate |
Ethyl octadeca-9,12-dienoate |
12 |
44.618 |
18.09 |
9-Octadecenoic acid, 1,2,3-propanetriyl ester, (E,E,E)- |
Propane-1,2,3-triyl tris (E)-octadec-9-enoate |
13 |
44.703 |
8.61 |
Trilinolein |
Propane-1,2,3-triyl tri(9Z,12Z)-octadeca-9,12-dienoate |
14 |
44.971 |
5.64 |
Glycidol stearate |
Oxiran-2-ylmethyl octadecanoate |
15 |
45.215 |
0.61 |
Ethanol, 2-(9,12-octadecadienyloxy)- |
2-[(9Z,12Z)-9,12-Octadecadien-1-yolxy] ethanol |
16 |
46.801 |
7.56 |
Dodecanoic acid, 1,2,3-propanetriyl ester |
1,2,3-propanetriyl tridodecanoate |
17 |
47.661 |
0.30 |
Triarachine |
Propane-1,2,3-triyl triicosanoate |
Antimicrobial activity
Antimicrobial potential of the purified fraction from S. cumini leaf extract were further evaluated by disc diffusion method. The purified fraction exhibits antibacterial and antifungal potential against S. aureus and Mucor sp. respectively (Figure 6). It produced a IZ of 21.77 ± 0.68 mm and 24.93 ± 0.80 mm against S. aureus and Mucor sp. respectively. It showed stronger activity towards the tested fungal culture than the tested bacterial culture. Antimicrobial potential of S. cumini leaf can be attributed to their major bioactive compounds including cis-9-hexadecenal (29.99%) and ethyl (9z,12z)-9,12-octadecadienoate (18.09%) along with other compounds including trilinolein (8.61%), dodecanoic acid 1,2,3-propanetriyl ester (7.56%), glycidol stearate comprised of 5.64%, and 9-Octadecenoic acid, methyl ester (1.31%) as detected by GC-MS analysis. Ciprofloxacin produced a IZ of 25.5 ± 0.50 mm. Nystatin produced a IZ of 19.67 ± 0.91 mm. Distilled water loaded disc does not produced any IZ indicating no antimicrobial activity against the tested bacterial and fungal cultures.
Figure 6. Antimicrobial activity of purified fraction against S. aureus and Mucor sp.
*T – Purified fraction, C – Ciprofloxacin (Positive control), N – Nystatin (Positive control), D – Distilled water (Negative control)
Antioxidant activity
The purified fraction from S. cumini leaf extract demonstrated a significant concentration-dependent increase in scavenging activity, with the percentage inhibition escalating from 30.8 ± 1.8% at 20 µg/mL to 84.2 ± 1.9% at 100 µg/mL (Figure 7). The half maximal inhibitory concentration (IC50) value was determined to be 56.75 µg/mL for the purified fraction, compared to 37.94 µg/mL for ascorbic acid. IC50 is the concentration that inhibits 50% of free radicals. The findings in this study underscore the potent antioxidant capacity of the purified fraction which can be attributed to their major bioactive compounds including cis-9-hexadecenal (29.99%) and ethyl (9z,12z)-9,12-octadecadienoate (18.09%) along with other compounds including trilinolein (8.61%), dodecanoic acid 1,2,3-propanetriyl ester (7.56%), glycidol stearate comprised of 5.64%, and 9-Octadecenoic acid, methyl ester (1.31%) as detected by GC-MS analysis.
In this study, a biologically active fraction exhibiting both antibacterial and antifungal activity was detected in the leaf extract of S. cumini through contact-TLC bioautography and purified using PTLC. Subsequently, the purified fraction was characterized using various analytical methods. UV-Vis spectroscopy exhibited a λmax peak at 224 nm, suggesting the presence of conjugated systems typical of phenolic compounds. ATR-FTIR spectroscopy analysis revealed important functional groups, such as O-H stretches (phenolic hydroxyl groups), C=C stretches (aromatic rings), and C=C stretches (alkynes), further verifying that phenolic compounds are present. The purified compounds demonstrated potent biological activities, exhibiting strong antibacterial and antifungal properties. Additionally, the antioxidant activity was assessed, yielding an IC50 value of 56.75 µg/mL, underscoring the significant antioxidant potential of these fraction. Collectively, these results highlighted the dual bioactivity (antimicrobial and antioxidant) of S. cumini leaf can be attributed to their major bioactive compounds including cis-9-hexadecenal (29.99%) and ethyl (9z,12z)-9,12-octadecadienoate (18.09%) along with other compounds including trilinolein (8.61%), dodecanoic acid 1,2,3-propanetriyl ester (7.56%), glycidol stearate comprised of 5.64%, and 9-Octadecenoic acid, methyl ester (1.31%), suggesting their potential utility in therapeutic strategies targeting microbial infections and oxidative stress-related pathologies.
ACKNOWLEDGMENTS
None.
CONFLICT OF INTEREST
The authors declare that there is no conflict of interest.
AUTHORS’ CONTRIBUTION
All authors listed have made a substantial, direct and intellectual contribution to the work, and approved it for publication.
FUNDING
None.
DATA AVAILABILITY
All datasets generated or analysed during this study are included in the manuscript.
ETHICS STATEMENT
Not Applicable.
- Dewanjee S, Gangopadhyay M, Bhattacharya N, Khanra R, Dua TK. Bioautography and its scope in the field of natural product chemistry. J Pharm Anal. 2015;5(2):75-84.
Crossref - Habsi AASA, Hossain MA. Isolation, structure characterization and prediction of antioxidant activity of two new compounds from the leaves of Dodonaea viscosa native to the Sultanate of Oman. Egypt J Basic Appl Sci. 2018;5:157-164.
Crossref - Suleimana MM, McGaw LJ, Naidoo V, Eloff J. Detection of antimicrobial compounds by bioautography of different extracts of leaves of selected South African tree species. Afr J Tradit Complement Altern Med. 2010;7(1):64-78.
Crossref - Hostettmann K, Wolfender J, Terreaux C. Modern screening techniques for plant extracts. Pharm Biol. 2001;39(Suppl 1):18-32.
Crossref - Bram S, Wolfram E. Recent Advances in Effect-directed Enzyme Assays based on Thin-layer Chromatography. Phytochem Anal. 2017;28(2):74-86.
Crossref - Grzelak EM, Hwang C, Cai G, et al. Bioautography with TLC-MS/NMR for Rapid Discovery of Anti tuberculosis Lead Compounds from Natural Sources. ACS Infect Dis. 2016;2(4):294-301
Crossref - Jahan S, Mahmud M, Khan Z, et al. Health promoting benefits of pongamol: An overview. Biomed Pharmacother. 2021;142:112109.
Crossref - Famuyide IM, Aro AO, Fasina FO, Eloff JN, McGaw LJ. Antibacterial and antibiofilm activity of acetone leaf extracts of nine under-investigated south African Eugenia and Syzygium (Myrtaceae) species and their selectivity indices. BMC Complement Altern Med. 2019;19:(1)141.
Crossref - Vaou N, Stavropoulou E, Voidarou C, Tsigalou C, Bezirtzoglou E. Towards Advances in Medicinal Plant Antimicrobial Activity: A Review Study on Challenges and Future Perspectives. Microorganisms. 2021;9(10):2041.
Crossref - Centers for Disease Control and Prevention. Antibiotic Resistance Threats in the United States, 2019. Atlanta, GA: U.S. 2019 Antibiotic Resistance Threats Report;Antimicrobial Resistance | CDC. Accessed 25 Feb, 2025.
- Food and Agriculture Organisation of the United Nations. Antimicrobial Resistance. https://www.fao.org/antimicrobial-resistance/background/what-is-it/en/ Accessed 5 December, 2024.
- Devi YA, Gnanasekaran P, Devi HJ. Antibacterial, Antioxidant and Cytotoxicity Assessment of Crassocephalum crepidioides Leaf Extract. J Pure Appl Microbiol. 2024;18(4):2528-2538.
Crossref - Phaniendra A, Jestadi DB, Peryasamy L. Free radicals:properties, sources, targets, and their implication in various diseases. Indian J Clin Biochem. 2015:30(1):11-26.
Crossref - Lobo V, Patil A, Phatak A, Chandra N. Free radicals, antioxidants and functional foods: Impact on human health. Pharmacogn Rev. 2010;4(8):118-126.
Crossref - Favier A. Oxidative stress in Human diseases. Ann Pharm Fr. 2006;64(6):390-396.
Crossref - Zouirech O, Alyousef AA, EI Barnossi A, et al. Phytochemical Analysis and Antioxidant, Antibacterial, and Antifungal Effects of Essential Oil of Black Caraway (Nigella sativa L.) seeds against Drug-Resistant Clinically Pathogenic Microorganisms. Biomed Res Int. 2022;2022(1):5218950.
Crossref - Faria AF, Marques MC, Mercadante AZ. Identification of bioactive compounds from jambolao (Syzygium cumini) and antioxidant capacity evaluation in different pH conditions. Food Chem. 2011;126(4):1571-1578.
Crossref - Chagas VT, Franca LM, Malik S, de Andrade Paes AM. Syzygium cumini (L.) skeels: a prominent source of bioactive molecules against cardiometabolic diseases. Front Pharmacol. 2015;6:259.
Crossref - Ayyanar M, Subash-Babu P. Syzygium cumini (L.) Skeels: a review of its phytochemical constituents and traditional uses. Asian Pac J Trop Biomed. 2012;2(3):240-246.
Crossref - Ruan ZP, Zhang LL, Lin YM. Evaluation of the antioxidant activity of Syzygium cumini leaves. Molecules (Basel, Switzerland). 2008;13(10):2545-2556.
Crossref - Imran M, Imran M, Khan S. Antibacterial activity of Syzigium cumini leaf extracts against multidrug resistant pathogenic bacteria. J App Pharm Sci. 2017;7(3):168-174.
Crossref - Devi HJ, Gnanasekaran P, Devi YA, Siva D, Jayashankar J. Investigation of the antimicrobial efficacy and cytotoxicity of a natural disinfectant Syzygium cumini (L.) Skeels leaf extract on Vero cell lines. J App Pharm Sci. 2025;15(1):125-132.
Crossref - Ajiboye BO, Ojo OA, Akuboh OS, Abiola OM, Idowu O, Amuzat AO. Anti-Hyperglycemic and Anti-Inflammatory Activities of Polyphenolic-Rich Extract of Syzygium cumini Linn Leaves in Alloxan-Induced Diabetic Rats. J Evid Based Integr Med. 2018;23:1-8.
Crossref - Roy A, Bhattacharya S, Pandey JN, Biswas M. Anti-inflammatory activity of Syzygium cumini leaf against experimentally induced acute and chronic inflammations in rodents. Altern Med Stud. 2011;1(1):e6.
Crossref - Rajauria G, Abu-Ghannam N. Isolation and Partial Characterization of Bioactive Fucoxanthin from Himanthalia elongata Brown Seaweed: A TLC-Based Approach. Int J Anal Chem. 2013;2013(1):802573.
Crossref - Annuryanti F, Isnaeni I, Darmawati A, Rosyidah I, Dwiana AN. Method Validation of Contact and Immersion TLC bioautography for Determination of Streptomycin Sulfate in Shrimp. Turk J Pharm Sci. 2020;17(3):254-258
Crossref - Bhalodia NR, Shukla VJ. Antibacterial and antifungal activities from leaf extracts of Cassia fistula L.: An ethnomedicinal plant. J Adv Pharm Technol Res. 2011;2(2):104-109.
Crossref - Ranjini HK, Raj SN, Baker S, et al. Bioautographic profiling of therapeutic metabolites from phytobiologic endosymbionts inhabiting Azadirachta indica L. The Microbe. 2025;6:100285.
Crossref - Kowalski S, Kowalska G. Phenolic acid contents in fruits of Aubergine (Solanum melongena L). Pol J Food Nutr Sci. 2005;14/55 (1):37-42.
- Keskin SY, Ayse A, Kurnia HFF. Analyses of phytochemical compounds in the flowers and leaves of Spiraea japonica var. fortunei using UV-VIS, FTIR, and LC-MS techniques. Heliyon. 2024;10(3):e25496.
Crossref - Wongsa P, Phatikulrungsun P, Prathumthong S. FT-IR characteristics, phenolic profiles and inhibitory potential against digestive enzymes of 25 herbal infusions. Sci Rep. 2022;12:6631.
Crossref - Arora S, Itankar P. Extraction, isolation and identification of flavonoid from Chenopodium album aerial parts. J Tradit Complement Med. 2018;8(4):476-482.
Crossref - Hoda S, Gupta L, Shankar J, Gupta AK, Vijayaraghavan P. cis-9-Hexadecenal, a Natural Compound Targeting Cell Wall Organization, Critical Growth Factor, and Virulence of Aspergillus fumigatus. ACS omega. 2020;5(17):10077-10088.
Crossref - Alves J, Gaspar H, Silva J, et al. Unravelling the Anti-Inflammatory and Antioxidant Potential of the Marine Sponge Cliona celata from the Portuguese Coastline. Marine Drugs. 2021;19(11):632.
Crossref - Adrian, Syahputra RA, Juwita NA, Astyka R, Lubis MF. Andaliman (Zanthoxylum acanthopodium DC.) a herbal medicine from North Sumatera, Indonesia: Phytochemical and pharmacological review. Heliyon. 2023;9(5):e16159.
Crossref - Sundari D, Handayani DS, Suryanti V. Chemical compositions, antioxidant and antibacterial activities of kepel (Stelechocarpus burahol) fruit flesh and peel extracts. Biodiversitas. 2023;24(9).
Crossref - Chan P, Tomlinson B. Antioxidant Effects of Chinese Traditional Medicine: Focus on Trilinolein Isolated from the Chinese Herb Sanchi (Panax pseudoginseng). J Clin Pharmacol. 2000;40(5):457-461.
Crossref - Shaaban MT, Ghaly MF, Fahmi SM. Antibacterial activities of hexadecenoic acid methyl ester and green synthesized silver nanoparticles against multidrug resistant bacteria. J Basic Microbio. 2021;61(6):557 568.
Crossref - Krishnamoorthy K, Subramaniam P. Phytochemical profiling of Leaf, Stem and Tuber Parts of Solena amplexicaulis (Lam.) Gandhi using GC MS. Int Sch Res Notices. 2014;2014(1):567409.
Crossref
© The Author(s) 2025. Open Access. This article is distributed under the terms of the Creative Commons Attribution 4.0 International License which permits unrestricted use, sharing, distribution, and reproduction in any medium, provided you give appropriate credit to the original author(s) and the source, provide a link to the Creative Commons license, and indicate if changes were made.